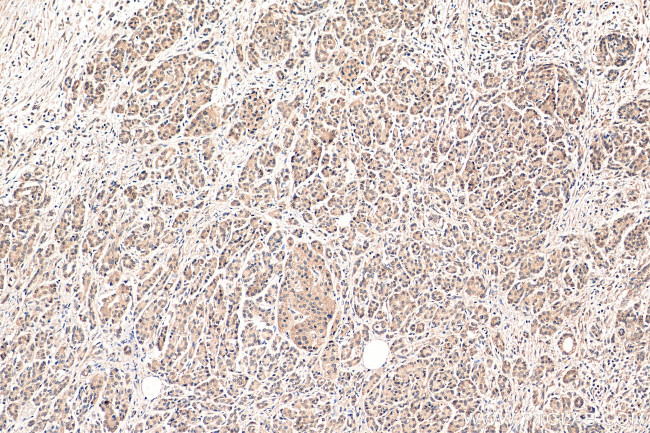
SBDS Antibody in Immunohistochemistry (Paraffin) (IHC (P))

Search
Proteintech
SBDS Polyclonal Antibody
{{$productOrderCtrl.translations['antibody.pdp.commerceCard.promotion.promotions']}}
{{$productOrderCtrl.translations['antibody.pdp.commerceCard.promotion.viewpromo']}}
{{$productOrderCtrl.translations['antibody.pdp.commerceCard.promotion.promocode']}}: {{promo.promoCode}} {{promo.promoTitle}} {{promo.promoDescription}}. {{$productOrderCtrl.translations['antibody.pdp.commerceCard.promotion.learnmore']}}









Please note: We are reviewing Western blot images included in the antibody testing data in our catalog, including those provided by third parties. Unless expressly labeled or annotated as “raw-unedited”, Western blot images included in the antibody testing data in our catalog may have been edited, optimized or otherwise adjusted for presentation.
Product Details
17618-1-AP
Species Reactivity
Published species
Host/Isotype
Class
Type
Immunogen
Conjugate
Form
Concentration
Amount
Purification
Storage buffer
Contains
Storage conditions
Shipping conditions
Product Specific Information
This antibody is a rabbit polyclonal antibody raised against a full-length human SBDS protein, recognizes specifically the 29 kDa SBDS protein.
Immunogen sequence: MSIFTPTNQ IRLTNVAVVR MKRAGKRFEI ACYKNKVVGW RSGVEKDLDE VLQTHSVFVN VSKGQVAKKE DLISAFGTDD QTEICKQILT KGEVQVSDKE RHTQLEQMFR DIATIVADKC VNPETKRPYT VILIERAMKD IHYSVKTNKS TKQQALEVIK QLKEKMKIER AHMRLRFILP VNEGKKLKEK LKPLIKVIES EDYGQQLEIV CLIDPGCFRE IDELIKKETK GKGSLEVLNL KDVEEGDEKF E (1-250 aa encoded by BC065700)
Target Information
This gene encodes a member of a highly conserved protein family that exists from archaea to vertebrates and plants. The encoded protein may function in RNA metabolism. Mutations within this gene are associated with Shwachman-Bodian-Diamond syndrome. An alternative transcript has been described, but its biological nature has not been determined. This gene has a closely linked pseudogene that is distally located.
For Research Use Only. Not for use in diagnostic procedures. Not for resale without express authorization.
Bioinformatics
Protein Aliases: FLJ10917; Protein 22A3; Ribosome maturation protein SBDS; Shwachman-Bodian-Diamond syndrome homolog; Shwachman-Bodian-Diamond syndrome protein; Shwachman-Bodian-Diamond syndrome protein homolog
Gene Aliases: 4733401P19Rik; AI836084; CGI-97; SBDS; SDS
UniProt ID: (Mouse) P70122, (Rat) Q5RK30
Entrez Gene ID: (Mouse) 66711, (Rat) 288615

Performance Guarantee
If an Invitrogen™ antibody doesn't perform as described on our website or datasheet,we'll replace the product at no cost to you, or provide you with a credit for a future purchase.*
Learn more
We're here to help
Get expert recommendations for common problems or connect directly with an on staff expert for technical assistance related to applications, equipment and general product use.
Contact tech support